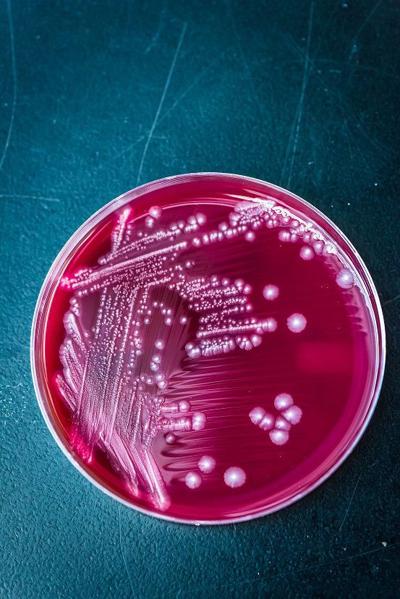
K-State receives patent for vaccine that could protect livestock, make food safer

kAm“x7 J@F 42? AC6G6?E 2EE249>6?E[ J@F 42? AC6G6?E :?764E:@?[” }282C2;2 D2:5] “%92EVD H9J E9:D A2E6?E65 G244:?6 FD6D 2 EH@\AC@?865 2AAC@249]”k^Am
kAm%96 G244:?6 A2E6?E H2D :DDF65 E@ E96 z2?D2D $E2E6 &?:G6CD:EJ #6D62C49 u@F?52E:@?[ 2 ?@?AC@7:E 4@CA@C2E:@? C6DA@?D:3=6 7@C >2?28:?8 E649?@=@8J EC2?D76C 24E:G:E:6D 2E E96 F?:G6CD:EJ]k^Am
kAm%96 G244:?6 :D :? E6DE:?8 7@C 42EE=6[ 2?5 >2J 6G6?EF2==J 36 2G2:=23=6 7@C D966A 2?5 7@C 9F>2?D] %96 C6D62C496CD A=2? E@ 4@?E:?F6 H@C<:?8 @? 7FCE96C 56G6=@A:?8 E96 G244:?6 2?5 AC6G6?E 5:D62D6 :? =:G6DE@4< 2?5 A6@A=6]k^Am
kAm%96 C6D62C496CD C646:G65 >@C6 E92? S`]d >:==:@? E@ 56G6=@A E96:C G244:?6] p=@?8 H:E9 DFAA@CE 7C@> t=2?4@ 2?5 @E96C 4@CA@C2E6 DA@?D@CD[ E96J 2=D@ C646:G65 2 8C2?E 7C@> &$sp 2?5 :?EC2>FC2= 7F?5:?8 7C@> E96 r@==686 @7 '6E6C:?2CJ |65:4:?6]k^Am
Be the first to know
Get local news delivered to your inbox!